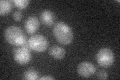
YNL172W
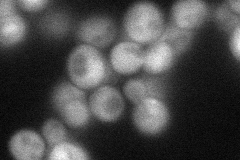
YNL172W
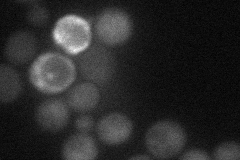
YNL172W
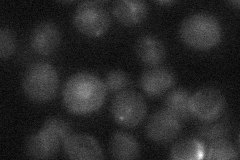
YNL172W
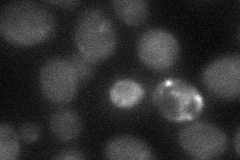
YNL172W
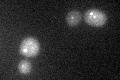
YNL172W

View description
Largest subunit of the Anaphase-Promoting Complex/Cyclosome (APC/C), which is a ubiquitin-protein ligase required for degradation of anaphase inhibitors, including mitotic cyclins, during the metaphase/anaphase transition
Localization:
Intensity:
Fold change:
Significance:
-
C’ GFP library in SD
nucleus18.96 -
N' NOP1pr-GFP in SD
cytosol46.6904 -
N' TEF2pr-mCherry in SD
below threshold19.7666 -
N' NATIVEpr-GFP in SD
nucleus21.6276 -
N' TEF2pr-VC and Cyto-VN in SD
cytosol29.9838 -
C’ GFP library in SD+DTT
punctateN/AN/ANo -
C’ GFP library in SD+H2O2

nucleus20.271.06No -
C’ GFP library in Starvation Media

nucleus16.940.89No -
C’ GFP library on the background of Pup2-DaMP

nucleus -
C’ GFP library on the background of CCT mutant

nucleus22.37991.17986No
